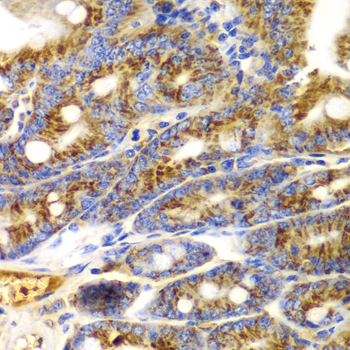
A2550: image 4

For quotations, please use our online quotation form, and you may also contact us by
sales@neoscientific.com
+1-888.733.6849
+1-617.299.7367 (Int’l)
+1-888.733.6849
+1-617.299.7367 (Int’l)
| Reactivity | Human Mouse Rat |
| Tested applications | WB IHC IF |
| Recommended Dilution | WB 1:500 - 1:2000 IHC 1:50 - 1:200 IF 1:50 - 1:200 |
| Calculated MW | 35kDa |
| Observed MW | Refer to Figures |
| Immunogen | Recombinant protein of human TNFSF11 |
| Storage Buffer | Store at -20℃. Avoid freeze / thaw cycles. Buffer: PBS with 0.02% sodium azide, 50% glycerol, pH7.3. |
| Synonym | ODF; OPGL; sOdf; CD254; OPTB2; RANKL; TRANCE; hRANKL2; |

Western blot analysis of extracts of various cell lines, using TNFSF11 antibody.

Immunohistochemistry of paraffin-embedded rat Intestine using TNFSF11 antibody at dilution of 1:100 (400x lens).

Immunohistochemistry of paraffin-embedded rat kidney using TNFSF11 antibody at dilution of 1:100 (400x lens).
Immunohistochemistry of paraffin-embedded mouse Intestine using TNFSF11 antibody at dilution of 1:100 (400x lens).

Immunohistochemistry of paraffin-embedded mouse kidney using TNFSF11 antibody at dilution of 1:100 (400x lens).

Immunofluorescence analysis of HeLa cell using TNFSF11 antibody. Blue: DAPI for nuclear staining.
This gene encodes a member of the tumor necrosis factor (TNF) cytokine family which is a ligand for osteoprotegerin and functions as a key factor for osteoclast differentiation and activation. This protein was shown to be a dentritic cell survival factor and is involved in the regulation of T cell-dependent immune response. T cell activation was reported to induce expression of this gene and lead to an increase of osteoclastogenesis and bone loss. This protein was shown to activate antiapoptotic kinase AKT/PKB through a signaling complex involving SRC kinase and tumor necrosis factor receptor-associated factor (TRAF) 6, which indicated this protein may have a role in the regulation of cell apoptosis. Targeted disruption of the related gene in mice led to severe osteopetrosis and a lack of osteoclasts. The deficient mice exhibited defects in early differentiation of T and B lymphocytes, and failed to form lobulo-alveolar mammary structures during pregnancy. Two alternatively spliced transcript variants have been found.
N/A